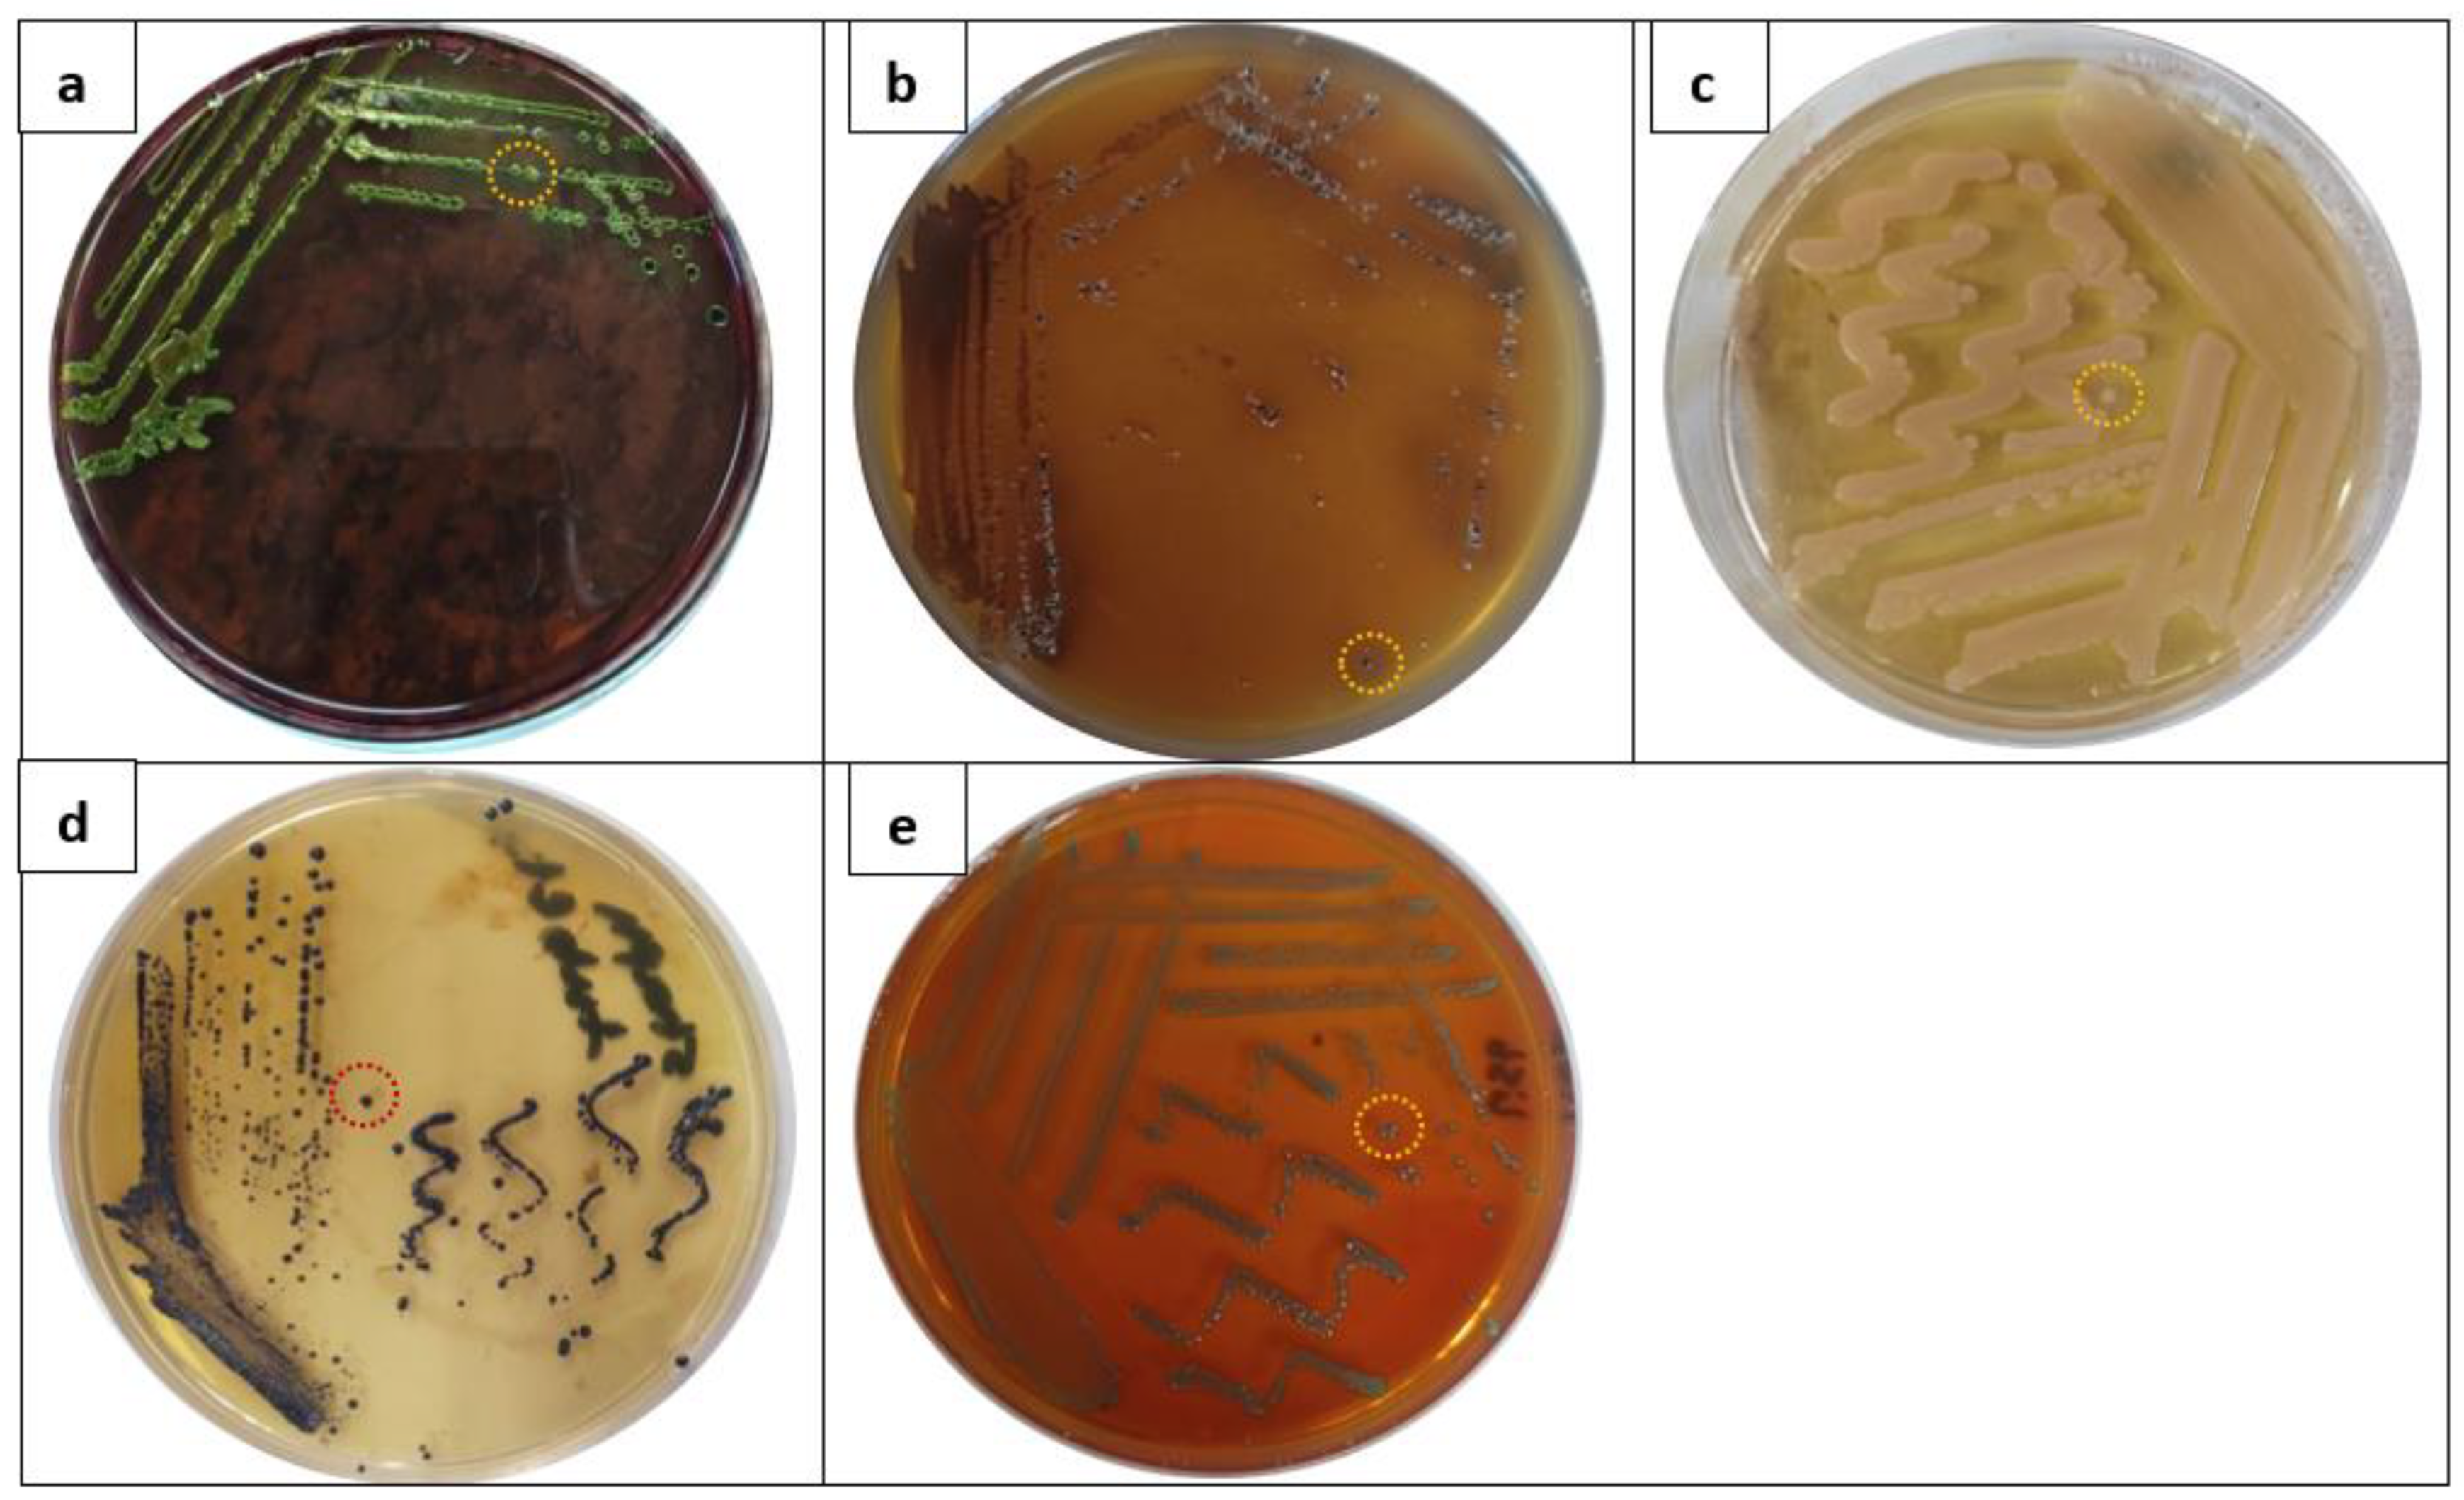
Molecules 28 03699 g004

Facile Synthesis, Characterization, and Antimicrobial Assessment of a Silver/Montmorillonite Nanocomposite as an Effective Antiseptic against Foodborne Pathogens for Promising Food Protection
Abstract
1. Introduction
2. Results and Discussion
| Pos. [°2Th.] | Height [cts] | Plane | Specie | References |
|---|---|---|---|---|
| 21.89 | 97.7 | 001 | NaMMT | [25] |
| 27.96 | 135.8 | 110 | Ag2O | [32] |
| 38.34 | 151.1 | 111 | Ag | [18,33,34] |
| 44.32 | 41.8 | 211 | Ag2O | [32] |
| 64.42 | 23.3 | 220 | Ag | [18,33] |
| 77.61 | 34.01 | 311 | Ag | [18,33] |
2.1. Isolation and Identification of Foodborne Bacterial Isolates from Food Samples
2.2. Antibacterial Evaluation
2.3. Estimation of MIC and MBC Values
2.4. Dose- and Time-Dependent Killing Action
2.5. Change in Bacterial Cell Morphology and Antibacterial Mechanisms of AgNPs@MMT
3. Materials and Methods
3.1. Chemicals
3.2. Synthesis of AgNPs/MMT Nanocomposites
3.3. Characterization Methods and Instruments
3.4. Analysis of Food Product Samples by the Cultural Method
Food Sample Collection and Preparation
3.5. Isolation and Identification of Foodborne Pathogens
3.6. Antimicrobial Evaluation
Stock Solutions
3.7. Inhibition Study Using Agar Diffusion Method
3.8. MIC and MBC Estimation
3.9. Dose- and Time-Dependent Killing Effect Assay
3.10. Morphological Change in Bacterial Cells
3.11. Statistical Analysis
4. Conclusions
Supplementary Materials
Author Contributions
Funding
Institutional Review Board Statement
Informed Consent Statement
Data Availability Statement
Acknowledgments
Conflicts of Interest
Sample Availability
References
- Malhotra, B.; Keshwani, A.; Kharkwal, H. Antimicrobial food packaging: Potential and pitfalls. Front. Microbiol. 2015, 6, 611. [Google Scholar] [CrossRef] [PubMed]
- Chawla, R.; Sivakumar, S.; Kaur, H. Antimicrobial edible films in food packaging: Current scenario and recent nanotechnological advancements—A review. Carbohydr. Polym. Technol. Appl. 2021, 2, 100024. [Google Scholar] [CrossRef]
- Bintsis, T. Foodborne pathogens. AIMS Microbiol. 2017, 3, 529–563. [Google Scholar] [CrossRef] [PubMed]
- Biji, K.B.; Ravishankar, C.N.; Mohan, C.O.; Srinivasa Gopal, T.K. Smart packaging systems for food applications: A review. J. Food Sci. Technol. 2015, 52, 6125–6135. [Google Scholar] [CrossRef] [PubMed]
- Kirk, M.D.; Pires, S.M.; Black, R.E.; Caipo, M.; Crump, J.A.; Devleesschauwer, B.; Döpfer, D.; Fazil, A.; Fischer-Walker, C.L.; Hald, T.; et al. World Health Organization Estimates of the Global and Regional Disease Burden of 22 Foodborne Bacterial, Protozoal, and Viral Diseases, 2010: A Data Synthesis. PLoS Med. 2015, 12, e1001921. [Google Scholar]
- Sofi, S.A.; Singh, J.; Rafiq, S.; Ashraf, U.; Dar, B.N.; Nayik, G.A. A Comprehensive Review on Antimicrobial Packaging and its Use in Food Packaging. Curr. Nutr. Food Sci. 2018, 14, 305–312. [Google Scholar] [CrossRef]
- Kumar, A.; Choudhary, A.; Kaur, H.; Mehta, S.; Husen, A. Metal-based nanoparticles, sensors, and their multifaceted application in food packaging. J. Nanobiotechnol. 2021, 19, 256. [Google Scholar] [CrossRef]
- Anvar, A.A.; Ahari, H.; Ataee, M. Antimicrobial Properties of Food Nanopackaging: A New Focus on Foodborne Pathogens. Front. Microbiol. 2021, 12, 690706. [Google Scholar] [CrossRef]
- Proulx, J.; Sullivan, G.; Marostegan, L.F.; VanWees, S.; Hsu, L.C.; Moraru, C.I. Pulsed light and antimicrobial combination treatments for surface decontamination of cheese: Favorable and antagonistic effects. J. Dairy Sci. 2017, 100, 1664–1673. [Google Scholar] [CrossRef]
- Zhong, Y.; Godwin, P.; Jin, Y.; Xiao, H. Advanced Industrial and Engineering Polymer Research Biodegradable polymers and green-based antimicrobial packaging materials: A mini-review. Adv. Ind. Eng. Polym. Res. 2020, 3, 27–35. [Google Scholar] [CrossRef]
- Dasgupta, N.; Ranjan, S.; Mundekkad, D.; Ramalingam, C.; Shanker, R.; Kumar, A. Nanotechnology in agro-food: From field to plate. Food Res. Int. 2015, 69, 381–400. [Google Scholar] [CrossRef]
- Franci, G.; Falanga, A.; Galdiero, S.; Palomba, L.; Rai, M.; Morelli, G.; Galdiero, M. Silver Nanoparticles as Potential Antibacterial Agents. Molecules 2015, 20, 8856–8874. [Google Scholar] [CrossRef]
- Youssef, A.M.; Abdel-Aziz, M.S. Preparation of Polystyrene Nanocomposites Based on Silver Nanoparticles Using Marine Bacterium for Packaging. Polym. Plast. Technol. Eng. 2013, 52, 607–613. [Google Scholar] [CrossRef]
- Nanda, A.; Saravanan, M. Biosynthesis of silver nanoparticles from Staphylococcus aureus and its antimicrobial activity against MRSA and MRSE. Nanomedicine 2009, 5, 452–456. [Google Scholar] [CrossRef]
- Valdés, A.; Garcia-Serna, E.; Martínez-Abad, A.; Vilaplana, F.; Jimenez, A.; Garrigós, M.C. Gelatin-Based Antimicrobial Films Incorporating Pomegranate (Punica granatum L.) Seed Juice by-Product. Molecules 2020, 25, 166. [Google Scholar] [CrossRef] [PubMed]
- Morsy, M.K.; Khalaf, H.H.; Sharoba, A.M.; El-Tanahi, H.H.; Cutter, C.N. Incorporation of Essential Oils and Nanoparticles in Pullulan Films to Control Foodborne Pathogens on Meat and Poultry Products. J. Food Sci. 2014, 79, M675–M684. [Google Scholar] [CrossRef]
- Paredes, D.; Ortiz, C.; Torres, R. Synthesis, characterization, and evaluation of antibacterial effect of Ag nanoparticles against Escherichia coli O157:H7 and methicillin-resistant Staphylococcus aureus (MRSA). Int. J. Nanomed. 2014, 9, 1717–1729. [Google Scholar] [CrossRef]
- Shameli, K.; Ahmad, M.B.; Yunus, W.M.Z.W.; Ibrahim, N.A.; Gharayebi, Y.; Sedaghat, S. Synthesis of silver/montmorillonite nanocomposites using γ-irradiation. Int. J. Nanomed. 2010, 2010, 1067–1077. [Google Scholar] [CrossRef]
- Chen, K.; Ye, W.; Cai, S.; Huang, L.; Zhong, T.; Chen, L.; Wang, X. Green antimicrobial coating based on quaternised chitosan/organic montmorillonite/Ag NPs nanocomposites. J. Exp. Nanosci. 2016, 11, 1360–1371. [Google Scholar] [CrossRef]
- Xu, G.; Qiao, X.; Qiu, X.; Chen, J. Preparation and Characterization of Nano-silver Loaded Montmorillonite with Strong Antibacterial Activity and Slow Release Property. J. Mater. Sci. Technol. 2011, 27, 685–690. [Google Scholar] [CrossRef]
- Li, Y.-T.; Lin, S.-B.; Chen, L.-C.; Chen, H.-H. Antimicrobial activity and controlled release of nanosilvers in bacterial cellulose composites films incorporated with montmorillonites. Cellulose 2017, 24, 4871–4883. [Google Scholar] [CrossRef]
- Loo, Y.Y.; Chieng, B.W.; Nishibuchi, M.; Radu, S. Synthesis of silver nanoparticles by using tea leaf extract from Camellia Sinensis. Int. J. Nanomed. 2012, 7, 4263–4267. [Google Scholar] [CrossRef]
- Ashraf, J.M.; Ansari, M.A.; Khan, H.M.; Alzohairy, M.A.; Choi, I. Green synthesis of silver nanoparticles and characterization of their inhibitory effects on AGEs formation using biophysical techniques. Sci. Rep. 2016, 6, 20414. [Google Scholar] [CrossRef] [PubMed]
- Elgorban, A.M.; El-Samawaty, A.E.-R.M.; Abd-Elkader, O.H.; Yassin, M.A.; Sayed, S.R.M.; Khan, M.; Farooq Adil, S. Bioengineered silver nanoparticles using Curvularia pallescens and its fungicidal activity against Cladosporium fulvum. Saudi J. Biol. Sci. 2017, 24, 1522–1528. [Google Scholar] [CrossRef] [PubMed]
- Praus, P.; Turicová, M.; Karlíková, M.; Kvítek, L.; Dvorský, R. Nanocomposite of montmorillonite and silver nanoparticles: Characterization and application in catalytic reduction of 4-nitrophenol. Mater. Chem. Phys. 2013, 140, 493–498. [Google Scholar] [CrossRef]
- Yan, H.; Chen, X.; Feng, Y.; Xiang, F.; Li, J.; Shi, Z.; Wang, X.; Lin, Q. Modification of montmorillonite by ball-milling method for immobilization and delivery of acetamiprid based on alginate/exfoliated montmorillonite nanocomposite. Polym. Bull. 2016, 73, 1185–1206. [Google Scholar] [CrossRef]
- Gashti, M.P.; Almasian, A. Synthesizing tertiary silver/silica/kaolinite nanocomposite using photo-reduction method: Characterization of morphology and electromagnetic properties. Compos. Part B Eng. 2012, 43, 3374–3383. [Google Scholar] [CrossRef]
- Ali, A.; Chiang, Y.W.; Santos, R.M. X-ray Diffraction Techniques for Mineral Characterization: A Review for Engineers of the Fundamentals, Applications, and Research Directions. Minerals 2022, 12, 205. [Google Scholar] [CrossRef]
- Padalia, H.; Moteriya, P.; Chanda, S. Green synthesis of silver nanoparticles from marigold flower and its synergistic antimicrobial potential. Arab. J. Chem. 2015, 8, 732–741. [Google Scholar] [CrossRef]
- Van Dong, P.; Ha, C.H.; Binh, L.T.; Kasbohm, J. Chemical synthesis and antibacterial activity of novel-shaped silver nanoparticles. Int. Nano Lett. 2012, 2, 9. [Google Scholar] [CrossRef]
- Azizi, M.; Sedaghat, S.; Tahvildari, K.; Derakhshi, P.; Ghaemi, A. Synthesis of silver nanoparticles using Peganum harmala extract as a green route. Green Chem. Lett. Rev. 2017, 10, 420–427. [Google Scholar] [CrossRef]
- Dhoondia, Z.H.; Chakraborty, H. Lactobacillus Mediated Synthesis of Silver Oxide Nanoparticles. Nanomater. Nanotechnol. 2012, 2, 15. [Google Scholar] [CrossRef]
- Omidi, S.; Sedaghat, S.; Tahvildari, K.; Derakhshi, P.; Motiee, F. Biosynthesis of silver nanocomposite with Tarragon leaf extract and assessment of antibacterial activity. J. Nanostruct. Chem. 2018, 8, 171–178. [Google Scholar] [CrossRef]
- Fernández Solarte, A.M.; Villarroel-Rocha, J.; Morantes, C.F.; Montes, M.L.; Sapag, K.; Curutchet, G.; Torres Sánchez, R.M. Insight into surface and structural changes of montmorillonite and organomontmorillonites loaded with Ag. C. R. Chim. 2019, 22, 142–153. [Google Scholar] [CrossRef]
- Bilal, M.; Rasheed, T.; Iqbal, H.M.N.; Li, C.; Hu, H.; Zhang, X. Development of silver nanoparticles loaded chitosan-alginate constructs with biomedical potentialities. Int. J. Biol. Macromol. 2017, 105, 393–400. [Google Scholar] [CrossRef] [PubMed]
- Lee, J.Y.H.; Monk, I.R.; Gonçalves da Silva, A.; Seemann, T.; Chua, K.Y.L.; Kearns, A.; Hill, R.; Woodford, N.; Bartels, M.D.; Strommenger, B.; et al. Global spread of three multidrug-resistant lineages of Staphylococcus epidermidis. Nat. Microbiol. 2018, 3, 1175–1185. [Google Scholar] [CrossRef] [PubMed]
- Sivanandy, P.; Thomas, B.; Krishnan, V.; Arunachalam, S. Safety and Efficacy of Thrombolytic Therapy Using rt-PA (Alteplase) in Acute Ischemic Stroke. ISRN Neurol. 2011, 2011, 618624. [Google Scholar] [CrossRef]
- Chen, S.F.; Li, J.P.; Qian, K.; Xu, W.P.; Lu, Y.; Huang, W.X.; Yu, S.H. Large scale photochemical synthesis of M@TiO2 nanocomposites (M = Ag, Pd, Au, Pt) and their optical properties, CO oxidation performance, and antibacterial effect. Nano Res. 2010, 3, 244–255. [Google Scholar] [CrossRef]
- Lara, H.H.; Ayala-Núñez, N.V.; Ixtepan Turrent, L.d.C.; Rodríguez Padilla, C. Bactericidal effect of silver nanoparticles against multidrug-resistant bacteria. World J. Microbiol. Biotechnol. 2010, 26, 615–621. [Google Scholar] [CrossRef]
- Anthony, K.J.P.; Murugan, M.; Gurunathan, S. Biosynthesis of silver nanoparticles from the culture supernatant of Bacillus marisflavi and their potential antibacterial activity. J. Ind. Eng. Chem. 2014, 20, 1505–1510. [Google Scholar] [CrossRef]
- Sharifi-Rad, J.; Hoseini Alfatemi, S.; Sharifi Rad, M.; Iriti, M. Antimicrobial Synergic Effect of Allicin and Silver Nanoparticles on Skin Infection Caused by Methicillin-Resistant Staphylococcus aureus spp. Ann. Med. Health Sci. Res. 2014, 4, 863–868. [Google Scholar] [CrossRef] [PubMed]
- Gopinath, V.; Priyadarshini, S.; Loke, M.F.; Arunkumar, J.; Marsili, E.; MubarakAli, D.; Velusamy, P.; Vadivelu, J. Biogenic synthesis, characterization of antibacterial silver nanoparticles and its cell cytotoxicity. Arab. J. Chem. 2017, 10, 1107–1117. [Google Scholar] [CrossRef]
- Yan, X.; He, B.; Liu, L.; Qu, G.; Shi, J.; Hu, L.; Jiang, G. Antibacterial mechanism of silver nanoparticles in: Pseudomonas aeruginosa: Proteomics approach. Metallomics 2018, 10, 557–564. [Google Scholar] [CrossRef] [PubMed]
- Gugala, N.; Lemire, J.; Chatfield-Reed, K.; Yan, Y.; Chua, G.; Turner, R.J. Using a Chemical Genetic Screen to Enhance Our Understanding of the Antibacterial Properties of Silver. Genes 2018, 9, 344. [Google Scholar] [CrossRef] [PubMed]
- Dakal, T.C.; Kumar, A.; Majumdar, R.S.; Yadav, V. Mechanistic Basis of Antimicrobial Actions of Silver Nanoparticles. Front. Microbiol. 2016, 7, 1831. [Google Scholar] [CrossRef]
- Salas-Orozco, M.; Niño-Martínez, N.; Martínez-Castañón, G.-A.; Méndez, F.T.; Jasso, M.E.C.; Ruiz, F. Mechanisms of Resistance to Silver Nanoparticles in Endodontic Bacteria: A Literature Review. J. Nanomater. 2019, 2019, 7630316. [Google Scholar] [CrossRef]
- Baird, B.R.; Rice, E.W.C.; Eaton, D.A. Standard Methods for the Examination of Water and Wastewater, 23rd ed.; American Public Health Association: Washington, DC, USA, 2017. [Google Scholar]
- Weiser, R.; Donoghue, D.; Weightman, A.; Mahenthiralingam, E. Evaluation of five selective media for the detection of Pseudomonas aeruginosa using a strain panel from clinical, environmental and industrial sources. J. Microbiol. Methods 2014, 99, 8–14. [Google Scholar] [CrossRef]
- Wragg, P.; Randall, L.; Whatmore, A.M. Comparison of Biolog GEN III MicroStation semi-automated bacterial identification system with matrix-assisted laser desorption ionization-time of flight mass spectrometry and 16S ribosomal RNA gene sequencing for the identification of bacteria of veterina. J. Microbiol. Methods 2014, 105, 16–21. [Google Scholar] [CrossRef]
- M11-A8; Methods for Antimicrobial Susceptibility Testing of Anaerobic Bacteria. Approved Standard-Eighth Edition. Clinical and Laboratory Standards Institute: Wayne, PA, USA, 2012.
- Bauer, A.W.; Kirby, W.M.; Sherris, J.C.; Turck, M. Antibiotic susceptibility testing by a standardized single disk method. Am. J. Clin. Pathol. 1966, 45, 493–496. [Google Scholar] [CrossRef]
- M07-A10; Methods for Dilution Antimicrobial Susceptibility Tests for Bacteria That Grow Aerobically. Approved Standard—10th Edition. CLSI: Wayne, PA, USA, 2015; ISBN 1562387839.
- Gholami-Shabani, M.; Akbarzadeh, A.; Norouzian, D.; Amini, A.; Gholami-Shabani, Z.; Imani, A.; Chiani, M.; Riazi, G.; Shams-Ghahfarokhi, M.; Razzaghi-Abyaneh, M. Antimicrobial activity and physical characterization of silver nanoparticles green synthesized using nitrate reductase from Fusarium oxysporum. Appl. Biochem. Biotechnol. 2014, 172, 4084–4098. [Google Scholar] [CrossRef]
- Alfuraydi, A.A.; Devanesan, S.; Al-Ansari, M.; AlSalhi, M.S.; Ranjitsingh, A.J. Eco-friendly green synthesis of silver nanoparticles from the sesame oil cake and its potential anticancer and antimicrobial activities. J. Photochem. Photobiol. B Biol. 2019, 192, 83–89. [Google Scholar] [CrossRef] [PubMed]
- Loo, Y.Y.; Rukayadi, Y.; Nor-Khaizura, M.A.R.; Kuan, C.H.; Chieng, B.W.; Nishibuchi, M.; Radu, S. In Vitro antimicrobial activity of green synthesized silver nanoparticles against selected Gram-negative foodborne pathogens. Front. Microbiol. 2018, 9, 1555. [Google Scholar] [CrossRef] [PubMed]

| Bacterial Isolates | Meat | Fish | Cheese | Vegetables | Total Samples | |||||
|---|---|---|---|---|---|---|---|---|---|---|
| +/No. of Isolates | % | +/No. of Isolates | % | +/No. of Isolates | % | +/No. of Isolates | % | +/Total No. of Isolates | % | |
| E. coli | 9/15 | 60 | 11/15 | 73.3 | 12/15 | 80 | 11/15 | 73.3 | 43/60 | 71.6 |
| Salmonella spp. | 11/15 | 73.3 | 12/15 | 80 | 8/15 | 53.3 | 10/15 | 66.6 | 41/60 | 68.3 |
| P. aureginosa | 10/15 | 66.6 | 9/15 | 60 | 7/15 | 46.6 | 5/15 | 33.3 | 31/60 | 51.6 |
| S. aureus | 10/15 | 66.6 | 8/15 | 53.3 | 5/15 | 33.3 | 6/15 | 40 | 29/60 | 48.3 |
| L. moncytogenes | 8/15 | 53.3 | 5/15 | 33.3 | 11/15 | 73.3 | 4/15 | 26.6 | 28/60 | 46.6 |
| B. cereus | 8/15 | 53.3 | 4/15 | 26.6 | 6/15 | 40 | 3/15 | 20 | 21/60 | 35 |
| Selected Bacterial Strains | Microdilution Assay (µg/mL) | ||
|---|---|---|---|
| MIC | MBC | ||
| G− bacterial strains | E. coli | 30 ± 0.25 | 45 ± 0.34 |
| P. aeruginosa | 15 ± 0.47 | 30 ± 0.58 | |
| Salmonella sp. | 30 ± 0.31 | 45 ± 0.12 | |
| G+ bacterial strains | S. aureus | 45 ± 0.29 | 60 ± 0.72 |
| L. monocytogenes | 75 ± 0.43 | 75 ± 0.39 | |
| B. cereus | 60 ± 0.53 | 60 ± 0.28 | |
Disclaimer/Publisher’s Note: The statements, opinions and data contained in all publications are solely those of the individual author(s) and contributor(s) and not of MDPI and/or the editor(s). MDPI and/or the editor(s) disclaim responsibility for any injury to people or property resulting from any ideas, methods, instructions or products referred to in the content. |
© 2023 by the authors. Licensee MDPI, Basel, Switzerland. This article is an open access article distributed under the terms and conditions of the Creative Commons Attribution (CC BY) license (https://creativecommons.org/licenses/by/4.0/).
Share and Cite
El-Sherbiny, M.M.; Devassy, R.P.; El-Hefnawy, M.E.; Al-Goul, S.T.; Orif, M.I.; El-Newehy, M.H. Facile Synthesis, Characterization, and Antimicrobial Assessment of a Silver/Montmorillonite Nanocomposite as an Effective Antiseptic against Foodborne Pathogens for Promising Food Protection. Molecules 2023, 28, 3699. https://doi.org/10.3390/molecules28093699
El-Sherbiny MM, Devassy RP, El-Hefnawy ME, Al-Goul ST, Orif MI, El-Newehy MH. Facile Synthesis, Characterization, and Antimicrobial Assessment of a Silver/Montmorillonite Nanocomposite as an Effective Antiseptic against Foodborne Pathogens for Promising Food Protection. Molecules. 2023; 28(9):3699. https://doi.org/10.3390/molecules28093699
Chicago/Turabian StyleEl-Sherbiny, Mohsen M., Reny P. Devassy, Mohamed E. El-Hefnawy, Soha T. Al-Goul, Mohammed I. Orif, and Mohamed H. El-Newehy. 2023. "Facile Synthesis, Characterization, and Antimicrobial Assessment of a Silver/Montmorillonite Nanocomposite as an Effective Antiseptic against Foodborne Pathogens for Promising Food Protection" Molecules 28, no. 9: 3699. https://doi.org/10.3390/molecules28093699
APA StyleEl-Sherbiny, M. M., Devassy, R. P., El-Hefnawy, M. E., Al-Goul, S. T., Orif, M. I., & El-Newehy, M. H. (2023). Facile Synthesis, Characterization, and Antimicrobial Assessment of a Silver/Montmorillonite Nanocomposite as an Effective Antiseptic against Foodborne Pathogens for Promising Food Protection. Molecules, 28(9), 3699. https://doi.org/10.3390/molecules28093699

